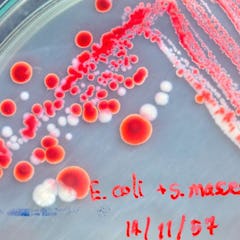
E.coli (STEC/ EHEC)

Belgische recalls en waarschuwingen november: mogelijke aanwezigheid van Escherichia coli in kaas
Dit zijn de Belgische recalls en veiligheidswaarschuwingen voor november. De laatste wapenfeiten: Mogelijke aanwezigheid van Escherichia coli in kaas, en allergeen tarwe niet vermeld op etiket bier.